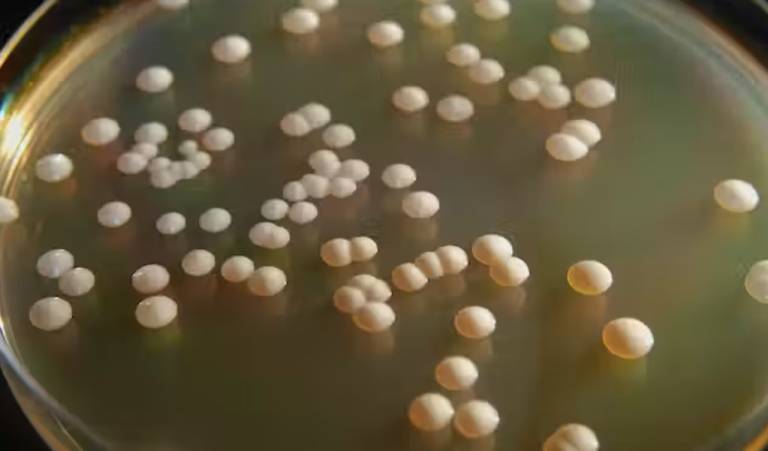

Microsporidia: Un Enemigo Silencioso en el Reino Fungi

Microsporidia representa un grupo de hongos unicelulares que han intrigado a la comunidad científica durante décadas. Son conocidos por su capacidad para infectar una variedad de huéspedes, incluyendo humanos, animales y otros microorganismos. 1. Definición: Microsporidia son hongos intracelulares obligatorios…